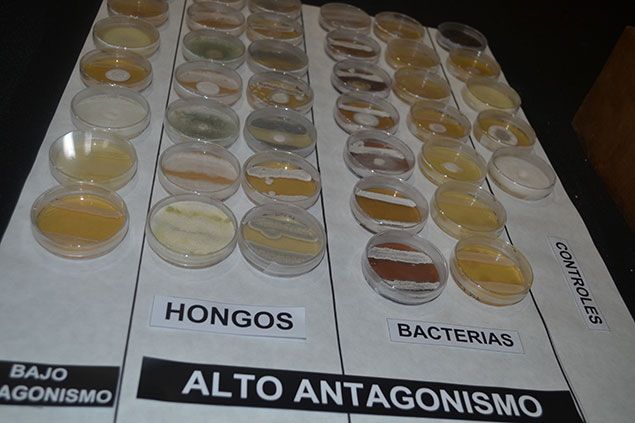
Muestras recogidas en Priaranza

Muestras recogidas en Priaranza
Muestras recogidas en Priaranza
Priaranza se ha convertido en escenario principal del proyecto que Inbiotec (Instituto de Biotecnología de León) está llevando a cabo junto a cinco socios de diferentes países europeos con el objetivo de encontrar una forma natural de proteger la madera frente a la degradación. Para conseguirlo, Carlos Barreiro, director científico del Instituto de Biotecnología de la Universidad de León y natural del municipio, ha recogido con la ayuda de los vecinos de Villavieja, 60 variedades de madera gracias a las que se han podido aislar 600 microorganismos distintos de los que ya han analizado 250. Según ha explicado Barreiro, 25 son buenos candidatos y van a empezar a probar con 12 de ellos.
El proyecto ProWood (Protección de la Madera), que cuenta con un plazo de 3 años y un presupuesto de 1,58 millones de euros de los que casi 200.000 corresponden a Inbiotec, ha sido presentado este jueves en el Castillo de Cornatel. La pretensión es generar barnices o pinturas, económicamente viables y ecológicas, que retrasen el crecimiento de los hongos en la madera e inhiban su proceso de degradación.
Tal como ha declarado Barreiro, actualmente la investigación relacionada con la descomposición de la madera se centra en dos líneas fundamentales, por un lado se estudía cómo acelerar este proceso para valorizar productos de origen vegetal y, por otro lado, prevenirlo, para lo que hoy en día se suelen utilizar productos de alta toxicidad.
Tras más de un año de trabajo, las muestras recogidas hasta el momento son esperanzadoras.
Así mismo, Barreiro ha sostenido que alrededor de un proyecto surgen siempre nuevas líneas de investigación , como el estudio de los microorganismos que producen antibióticos, y también grandes posibilidades formativas.

